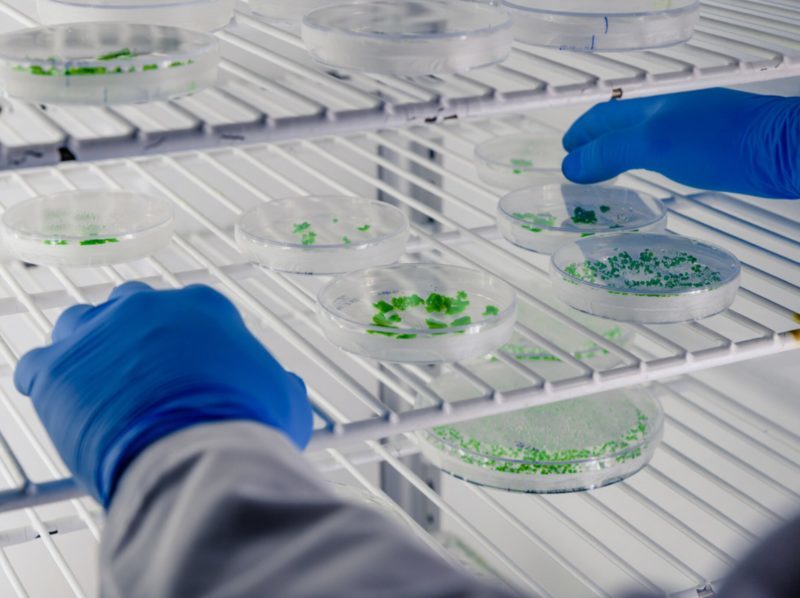
Aplicación de bacterias para la recuperación de suelos afectados por residuos plásticos

Aplicación de bacterias para la recuperación de suelos afectados por residuos plásticos
Un equipo de investigación de la Universidad de Almería ha logrado una mezcla efectiva contra la contaminación de plásticos en los suelos. La estrategia combina compost y microorganismos que digieren los residuos sintéticos para convertirlos en materia orgánica. Las bacterias sobreviven hasta 1000 veces más que con otros métodos probados, lo que permite que su acción sea más duradera y eficiente. Además, la tasa de degradación de plástico es hasta un 50% superior que con otras técnicas utilizadas. El uso de plásticos en la agricultura que persisten como residuos contaminantes alteran la estructura del suelo, reduciendo su capacidad de retener agua y aire, interfieren en la microbiota que recicla nutrientes, liberan aditivos tóxicos y pueden incluso penetrar en las raíces de algunos cultivos, afectando a su crecimiento y a la calidad de los alimentos. En el artículo ‘Effective microbial formulations using sustainable carriers for the remediation of plastic-affected soils’ de la revista Journal of Environmental Management, los expertos han aplicado con éxito una estrategia basada en la unión de distintos tipos de microorganismos con sustratos orgánicos para la regeneración de suelos contaminados.
En él evaluaron cómo mantener vivos y activos a los microbios degradadores antes de aplicarlos al suelo. Tras las pruebas, concluyeron que el vermicompost, un abono tratado con lombrices, y el biochar, obtenido del calentamiento de residuos orgánicos, son los aliados más eficaces, ya que su unión conserva mejor la viabilidad y la actividad de las bacterias y aumenta su capacidad de descomponer plásticos. En otro artículo, ‘Co-application of organic amendment and plastic-degrading microbial inoculum drives functional microbial shifts in plastic-contaminated soils’ de la revista Environmental Technology & Innovation, han analizado cómo es la acción de los microorganismos una vez que llegan al suelo y lo modifican. Además, han conseguido obtener un cóctel bacteriano que, junto al compost, consigue mejorar la degradación del plástico y la regeneración del entorno entre un 35 y un 50% superior a otras técnicas.
Los microplásticos actúan como esponjas que acumulan pesticidas y contaminantes, lo que aumenta los riesgos de toxicidad. “Todo esto convierte a los suelos en una puerta de entrada de microplásticos a la cadena alimentaria humana y animal. La importancia de elaborar estrategias que rectifiquen la contaminación es prioritaria”, indica a la Fundación Descubre la investigadora de la Universidad de Almería Macarena Jurado, coautora del artículo. Así, demuestran que su propuesta de combinar los microorganismos con compost u otras enmiendas amplifica su eficacia y duración, logrando la recuperación de suelos agrícolas. “Esta estrategia que unifica la aplicación conjunta de materia orgánica y degradadores de plástico puede ser una alternativa efectiva y sostenible para rehabilitar sustratos contaminados, ya que estimula cambios favorables en la comunidad microbiana y potencia la eliminación de contaminantes”, añade la investigadora.
Un matrimonio bien avenido
Los investigadores compararon distintos sustratos sostenibles como biochar, obtenido del calentamiento de residuos orgánicos, vermicompost, producido con la ayuda de lombrices, y perlas de alginato, pequeñas esferas hechas a partir de un polisacárido natural que se extrae de algas marinas. El objetivo era localizar qué fórmula sostenible es más efectiva para contener e introducir microorganismos que degradan plástico en suelos contaminados, y así crear una herramienta biotecnológica para su descontaminación. Se utilizaron cultivos puros y combinaciones de Bacillus subtilis y Pseudomonas alloputida, ambos con capacidad para descomponer materia plástica. Tras un periodo de almacenamiento, se midió tanto la viabilidad celular, es decir, la cantidad de microorganismos sobrevivientes, y la actividad enzimática relacionada con la degradación del plástico, en la que se evalúa el nivel de ocupación de los microbios trabajando para descomponerlo. También se analizó el proceso de mineralización de los residuos sintéticos durante dos meses, la forma más completa de restauración, ya que el material original deja de existir como residuo y se transforma en CO₂, agua y biomasa.
De esta manera, determinaron que la opción más eficiente consiste en una combinación de biochar, vermicompost y urea como mejor enmienda para la restauración de los suelos. Además, concretaron que existe una densidad óptima de microbios, suficiente para degradar eficientemente el plástico, pero sin saturar el sistema, ya que demasiados microorganismos podían competir por nutrientes y reducir la eficiencia. Los investigadores plantean la posibilidad de trasladar estos hallazgos al campo, evaluando la eficacia, seguridad y sostenibilidad de aplicar estas técnicas a gran escala, con el objetivo de crear suelos más saludables y resilientes mientras se reduce la contaminación. Además, siguen valorando nuevas combinaciones para identificar consorcios microbianos especializados y estudiar las interacciones entre microplásticos, suelo y biodiversidad microbiana.
Este estudio fue financiado por la Empresa Común de Industrias de Base Biológica (BBI-JU) en el marco del programa de investigación e innovación Horizonte 2020 de la Unión Europea.








